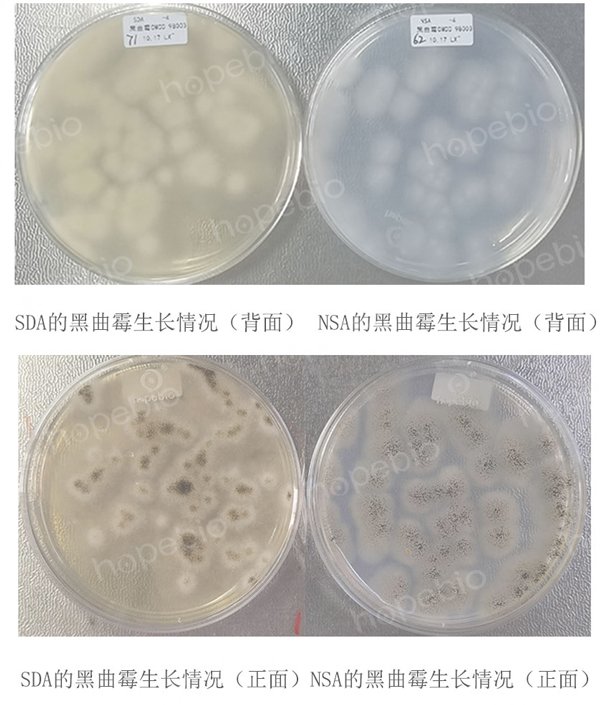

营养盐琼脂培养基(NSA)/用于漆膜耐霉菌性的测定
-
MH液体试管
BNCC391763 | 见详情
-
中国蓝培养基即用型平板
BNCC391618 | 见详情
-
肉汤培养基G(麦康凯肉汤)
BNCC391158 | 见详情
-
EG肉汤培养基
BNCC390941 | 见详情
-
蛋白瘤胃球菌培养基基础(含纤维二糖)
BNCC389132 | 见详情



用途:用于漆膜耐霉菌性的测定。
原理:
培养基中的硝酸钠提供氮源;磷酸盐提供缓冲体系;氯化钾、硫酸镁和硫酸亚铁中的金属离子提供霉菌生长所必需的微量元素;蔗糖提供碳源;琼脂是培养基的凝固剂。
成分(g/L)称取本品25.0g,加热煮沸完全溶解于1000ml蒸馏水中,分装,121℃高压灭菌20分钟,冷至50℃左右时,倾入无菌平皿备用。
营养盐琼脂培养基(NSA)微生物质控结果
营养盐琼脂培养基(NSA)微生物灵敏度试验:按标签用法制备培养基,接种以下质控菌株,放置20-25℃需氧培养72-120小时。
以上信息仅供参考,请以实物批次为准!
本公司销售的所有产品仅供实验科研使用,不用于人体及临床诊断。
2. 接种:在样品表面均匀喷洒霉菌孢子悬浮液。
3. 培养:将接种后的样品放入恒温恒湿培养箱(温度28℃±1℃,相对湿度≥85%)中培养28天。
4. 观察记录:定期检查霉菌生长情况,记录菌落形态及覆盖率[7][8]。
2. 定量限:依据菌落覆盖率分级(如0级:无生长;4级:覆盖率>75%),半定量评估霉菌生长程度[7][8]。
2. 阴性对照:未接种的培养基及样品,排除环境交叉污染。
3. 菌种验证:试验菌株(如黑曲霉CMCC(F)98003)需在沙氏葡萄糖琼脂(SDA)上验证活性及纯度[7][8]。
2. 孢子悬浮液制备:用无菌生理盐水稀释霉菌孢子至浓度1×10⁶ CFU/mL。
3. 培养条件控制:保持湿度≥85%,避免培养基干燥影响霉菌生长[7][8]。
2. 安全防护:操作人员需佩戴防护装备,避免吸入霉菌孢子。
3. 结果判定:需由两名以上实验人员独立评估,减少主观误差[7][8]。
以上信息仅供参考,请以相应标准的原文为准!